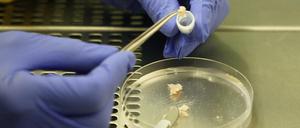

Die Linke spricht im Bundestag von einem „Kriegsabenteuer“, die Verteidigungsministerin von „bitterem Ernst“. Es war eine emotionale Debatte - dem Anlass angemessen.

Die Linke spricht im Bundestag von einem „Kriegsabenteuer“, die Verteidigungsministerin von „bitterem Ernst“. Es war eine emotionale Debatte - dem Anlass angemessen.

Die Bundeswehr will Tornados gegen den IS einsetzen. Doch der Zustand vieler Flugzeuge ist unbefriedigend. Die Verteidigungsministerin sieht darin kein Problem.

Verteidigungsministerin Ursula von der Leyen und Außenminister Frank-Walter Steinmeier werben für gemeinsames Vorgehen gegen IS in Syrien.
Die Regierungsparteien meiden das Wort "Krieg" für den Einsatz der Bundeswehr im Kampf gegen den IS. Doch gefährlich ist die Mission in Syrien. Was steht für Deutschland auf dem Spiel?

Die Regierung hat das Mandat für den Syrien-Einsatz der Bundeswehr auf den Weg gebracht. Eine Mehrheit der Deutschen fürchtet, dass dadurch die Terrorgefahr in Deutschland wächst.

Um den IS zu besiegen, braucht der Westen Bodentruppen. Womöglich auch die des syrischen Diktators. Deutlich aussprechen will das aber bisher kaum ein Politiker.

Francois Hollande hat den EU-Bündnisfall ausgerufen, um Europa auf den Kriegspfad zu führen. Das ist der Situation nicht angemessen, findet unser Autor.

Es ist die bislang größte Mission der Bundeswehr im Ausland. Generalinspekteur Volker Wieker gibt schon mal Details zum Syrien-Einsatz bekannt. Ursula von der Leyen schließt eine Beteiligung syrischer Regierungstruppen nicht aus.

Zerfließende Grenzen: Herfried Münkler erklärt in seinem neuen Buch „Kriegssplitter“, wie Konflikte im 21. Jahrhundert verlaufen.

Die Bundeswehr soll sich am Kampf gegen den IS beteiligen. Die Planungen laufen auf Hochtouren - militärisch und politisch. Die Opposition zweifelt an der völkerrechtlichen Legitimation.

Frankreichs Präsident Francois Hollande fordert von Deutschland und Russland militärische Unterstützung in Syrien. Was wird die Bundeswehr beitragen?

Kurswechsel in der Syrien-Politik: Deutschland wird sich militärisch am Kampf gegen den IS beteiligen. Der Bundestag soll zügig darüber abstimmen.

Frankreichs Präsident François Hollande kann nach den Anschlägen von Paris auf deutsche Hilfe im Anti-Terror-Kampf setzen. Kanzlerin Angela Merkel zeigt sich bei ihrem Besuch in Paris zu weiterer Unterstützung bereit.

Deutschland will Frankreich im Kampf gegen den Terror unterstützen und verstärkt deshalb seinen Einsatz in Mali.

Sein Name ist ein Pseudonym: Der Plagiatssucher "Robert Schmidt" hat Ursula von der Leyens Doktorarbeit für "VroniPlag Wiki" untersucht. Hier spricht er über verdächtige Stellen und den Grund für seine Anonymität.

Wenn sie aktiv werden, müssen Politiker zittern: „VroniPlag Wiki“ prüft auch Doktorarbeiten von Abgeordneten und Ministern. Wer steckt hinter der Plattform?

Der Kampf gegen den "Islamischen Staat" muss sowohl in Syrien geführt werden wie auch in Europa. Was getan wird und getan werden muss - Fragen und Antworten zum Thema.

Frankreich hat die IS-Hochburg Raqqa in Syrien angegriffen. Polizei fahndet nach Verdächtigem Abdeslam Salah. Die Ereignisse des Sonntags im Ticker zum Nachlesen.

Der Fall Ursula von der Leyen und die Folgen: Was die Medizin gegen ihre Qualitätsprobleme bei Dissertationen tut und wie Fehlverhalten konsequenter verfolgt werden kann.

"Ihr könnt euch darauf verlassen, dieser Staat wird euch nicht missbrauchen", sagte die Verteidigungsministerin zu den Soldaten. Die Bundeswehr feiert ihren 60. Geburtstag. 350 Bürger demonstrierten dagegen.

Vor 60 Jahren erhielten die ersten 100 Soldaten ihre Ernennungsurkunde. Dies feiert die Bundeswehr mit einem "Großen Zapfenstreich" am Reichstag.

Die Bundeswehr wird neuerdings als Instrument der Außenpolitik gesehen. Also muss das Land in sie investieren, fordert der Sicherheitsexperte.

Nach zehn Jahren erscheint das neue Weißbuch zur Sicherheitspolitik. Der Ansatz der Verteidigungsministerin ist revolutionär, sagt der Ex-General.
GESCHICHTEDas Bildungs- und Teilhabepaket (BuT) führte die damalige Arbeitsministerin Ursula von der Leyen (CDU) 2011 ein. Sie reagierte auf die Rechtsprechung des Bundesverfassungsgerichts im Rahmen der Hartz-IV-Reform.

Ursula von der Leyen hat dem Irak weitere Militärhilfe zugesagt. "Es ist unser gemeinsames Interesse, den IS zu bezwingen", sagte die Verteidigungsministerin.

Die Bundeswehr bietet seit Wochen Hilfe in der Flüchtlingskrise an. Doch Bund und Länder nehmen das nur zögerlich an.

Die Bundesregierung erwägt, die Bundeswehr für die Abschiebung von Flüchtlingen zu nutzen. Dabei könnte sie sich vor allem um den Transport kümmern. Die Opposition kritisiert die Überlegung scharf.

Neuer Vorwurf gegen Ursula von der Leyen: Verstieß sie bei ihrer Dissertation gegen ethische Grundsätze der medizinischen Forschung?

Um die afghanischen Sicherheitskräfte zu unterstützen, sollen mehr US-Soldaten als geplant am Hindukusch bleiben. Verteidigungsministerin von der Leyen begrüßt die Entscheidung

Ein Bericht widerlegt die Qualifizierung des G36 als „Pannengewehr“. Das Verteidigungsministerium will es trotzdem ausmustern.
Von der Leyen und die Folgen: Die akademische Unkultur bei Promotionen in der Medizin muss aufhören, schreibt der Mediziner und ehemalige HRK-Chef Peter Gaehtgens.

Beim Treffen der Innenminister mit der Kanzlerin wurde "Dampf abgelassen" - und über Transitzonen an deutschen Grenzen diskutiert. Die aber werden mit der SPD kaum zu machen sein, wie Justizminister Maas deutlich machte.

Die US-Universität Stanford zieht ihren Vorwurf zurück, Verteidigungsministerin Ursula von der Leyen habe den Namen der Uni missbräuchlich in ihrem Lebenslauf geführt.

Ursula von der Leyen nennt in ihrem Lebenslauf Stationen an der Eliteuni - angeblich zu Unrecht. Eine Stanford-Kennerin verteidigt die Ministerin aber.

Zwei Vorstände des Deutschen Instituts für Wirtschaftsforschung verteidigen Ursula von der Leyen: Wurde in der Medizin in den 90ern generell ungenau zitiert, treffe die Ministerin kein Vorwurf.

Nicht Vroniplag Wiki müsse abgeschaltet werden, sondern wissenschaftliches Fehlverhalten, fordert Gerhard Dannemann. Er antwortet auf einen Debattenbeitrag zweier DIW-Vorstände.

Die Familie Leyen pflegt enge Verbindungen zur Medizinischen Hochschule Hannover. Ist die Uni in der Plagiatsaffäre also befangen? Ein Sprecher weist das zurück.

In Afghanistan waren die lokalen Helfer für die Bundeswehr sehr wichtig. Viele fürchten jetzt um ihr Leben, doch nur jeder Zweite darf nach Deutschland.

Dass Ursula von der Leyen mit den Plagiatsvorwürfen zu ihrer Doktorarbeit mal nicht brillant und perfekt wirkt, findet Bernd Matthis eher beruhigend.

Die Taliban haben Kundus erobert, nun setzt die afghanische Regierung zum Gegenschlag an. Das US-Militär fliegt Luftangriffe. Der Fall von Kundus löst eine Debatte über den geplanten Abzug der Bundeswehr aus Nordafghanistan aus.
öffnet in neuem Tab oder Fenster